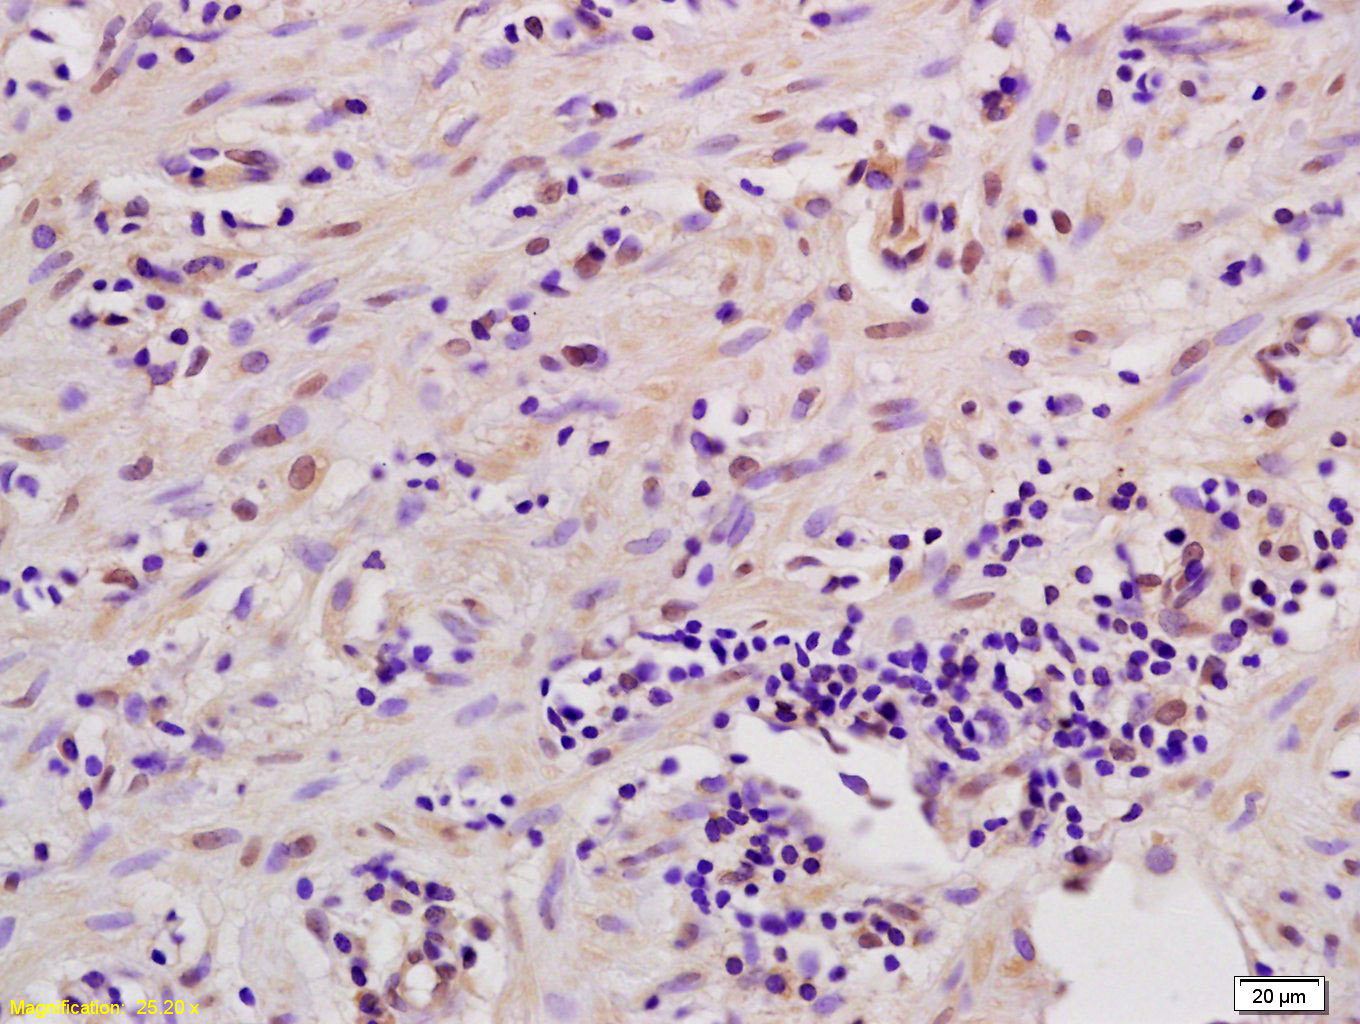
产品细节图片1

相关产品推荐更多 >
万千商家帮你免费找货
0 人在求购买到急需产品
- 详细信息
- 文献和实验
- 技术资料
- 应用范围:
产品信息以Bioss网站为准
- 规格:
50ul/100ul/200ul
| 规格: | 50ul | 产品价格: | ¥1180.0 |
|---|---|---|---|
| 规格: | 100ul | 产品价格: | ¥1980.0 |
| 规格: | 200ul | 产品价格: | ¥2800.0 |
| 产品编号 | bs-2995R |
| 英文名称 | MSK1 Rabbit pAb |
| 中文名称 | 有丝分裂原和应激活化型蛋白激酶1抗体 |
| 英文别名 | MSK1; RPS6KA5; 90 kDa ribosomal protein S6 kinase 5; EC 2.7.11.1; KS6A5_HUMAN; MGC1911; Mitogen and stress activated protein kinase 1; MSPK1; Nuclear Mitogen And Stress Activated Protein Kinase 1; Nuclear mitogen-and stress-activated protein kinase 1; Ribosomal protein S6 kinase 90kD polypeptide 5; Ribosomal protein S6 kinase 90kDa; Ribosomal protein S6 kinase 90kDa polypeptide 5; Ribosomal Protein S6 Kinase alpha 5; Ribosomal protein S6 kinase alpha-5; RLPK; RSK Like Protein Kinase; RSK-like protein kinase; RSKL; S6K alpha 5; S6K-alpha-5. |
| 产品应用 | WB=1:500-2000, IHC-P=1:100-500, IHC-F=1:100-500, IF=1:100-500 Not yet tested in other applications. |
| 交叉反应 | Human (Mouse, Rat, Chicken, Dog, Pig, Cow, Horse, Rabbit) |
| 抗体来源 | Rabbit |
| 免疫原 | KLH conjugated synthetic peptide derived from human MSK1 |
| 亚型 | IgG |
| 性状 | Liquid |
| 纯化方法 | affinity purified by Protein A |
| 克隆类型 | Polyclonal |
| 理论分子量 | 90 kDa |
| 浓度 | 1mg/ml |
| 储存液 | 0.01M TBS (pH7.4) with 1% BSA, 0.02% Proclin300 and 50% Glycerol. |
| 研究领域 | Cell Biology > Other Antibodies > Oxidative Stress Epigenetics and Nuclear Signaling > Transcription > Other factors Metabolism > Pathways and Processes > Redox metabolism > Oxidative stress Signal Transduction > Protein Phosphorylation > Ser / Thr Kinases > Other Kinases Signal Transduction > Protein Phosphorylation > Tyrosine Kinases > Receptor Tyrosine Kinases |
| 亚基 | Forms a complex with either MAPK1/ERK2 or MAPK3/ERK1 in quiescent cells which transiently dissociates following mitogenic stimulation. Also associates with MAPK14/p38-alpha. Activated RPS6KA5 associates with and phosphorylates the NF-kappa-B p65 subunit RELA. Interacts with CREBBP and EP300. |
| 亚细胞定位 | Nucleus. Cytoplasm. Note=Predominantly nuclear. Exported into cytoplasm in response to glucocorticoid. |
| 组织特异性 | Widely expressed with high levels in heart, brain and placenta. Less abundant in lung, kidney and liver. |
| 翻译后修饰 | Ser-376 and Thr-581 phosphorylation is required for kinase activity. Ser-376 and Ser-212 are autophosphorylated by the C-terminal kinase domain, and their phosphorylation is essential for the catalytic activity of the N-terminal kinase domain. Phosphorylated at Ser-360, Thr-581 and Thr-700 by MAPK1/ERK2, MAPK3/ERK1 and MAPK14/p38-alpha. Autophosphorylated at Ser-750, Ser-752 and Ser-758 by the N-terminal kinase domain. |
| 相似性 | Belongs to the protein kinase superfamily. AGC Ser/Thr protein kinase family. S6 kinase subfamily. Contains 1 AGC-kinase C-terminal domain. Contains 2 protein kinase domains. |
| 功能 | Serine/threonine-protein kinase that is required for the mitogen or stress-induced phosphorylation of the transcription factors CREB1 and ATF1 and for the regulation of the transcription factors RELA, STAT3 and ETV1/ER81, and that contributes to gene activation by histone phosphorylation and functions in the regulation of inflammatory genes. Phosphorylates CREB1 and ATF1 in response to mitogenic or stress stimuli such as UV-C irradiation, epidermal growth factor (EGF) and anisomycin. Plays an essential role in the control of RELA transcriptional activity in response to TNF and upon glucocorticoid, associates in the cytoplasm with the glucocorticoid receptor NR3C1 and contributes to RELA inhibition and repression of inflammatory gene expression. In skeletal myoblasts is required for phosphorylation of RELA at 'Ser-276' during oxidative stress. In erythropoietin-stimulated cells, is necessary for the 'Ser-727' phosphorylation of STAT3 and regulation of its transcriptional potential. Phosphorylates ETV1/ER81 at 'Ser-191' and 'Ser-216', and thereby regulates its ability to stimulate transcription, which may be important during development and breast tumor formation. Directly represses transcription via phosphorylation of 'Ser-1' of histone H2A. Phosphorylates 'Ser-10' of histone H3 in response to mitogenics, stress stimuli and EGF, which results in the transcriptional activation of several immediate early genes, including proto-oncogenes c-fos/FOS and c-jun/JUN. May also phosphorylate 'Ser-28' of histone H3. Mediates the mitogen- and stress-induced phosphorylation of high mobility group protein 1 (HMGN1/HMG14). In lipopolysaccharide-stimulated primary macrophages, acts downstream of the Toll-like receptor TLR4 to limit the production of pro-inflammatory cytokines. Functions probably by inducing transcription of the MAP kinase phosphatase DUSP1 and the anti-inflammatory cytokine interleukin 10 (IL10), via CREB1 and ATF1 transcription factors. Plays a role in neuronal cell death by mediating the downstream effects of excitotoxic injury. |
| 保存条件 | Shipped at 4℃. Store at -20℃ for one year. Avoid repeated freeze/thaw cycles. |
| 注意事项 | This product as supplied is intended for research use only, not for use in human, therapeutic or diagnostic applications. |
| 背景资料 | MSK1 is a mitogen and stress activated protein kinase 1 which belongs to the AGC family of kinases and is related in structure to the ribosomal p70 S6 kinase subfamily. MSK1 can be activated by ERK1/2 and SAPK2/p38 MAP kinase. It is also known to be required for the phosphorylation of CREB, ATF1 H3 and HMG14 in response to mitogen and stress. Similar to RSK, MSK1 contains two kinase domains (N term and a C term). Once phosphorylated on Thr581 and Ser360 by ERK1/2 and SAPK2/p38, MSK1 autophosphorylate on at least 5 sites. Of these autophosphorylation sites Ser212 and Ser376 get phosphorylated by the C terminal kinase domain of MSK1 which is essential for the catalytic activity of the N terminal kinase domain. |
| 应用 | 推荐稀释比例 |
| {WB} | {1:500-2000} |
| {IHC-P} | {1:100-500} |
| {IHC-F} | {1:100-500} |
| {IF} | {1:100-500} |
Antigen retrieval: citrate buffer ( 0.01M, pH 6.0 ), Boiling bathing for 15min; Block endogenous peroxidase by 3% Hydrogen peroxide for 30min; Blocking buffer (normal goat serum,C-0005) at 37℃ for 20 min;
Incubation: Anti-MSK1/RPS6KA5 Polyclonal Antibody, Unconjugated(bs-2995R) 1:200, overnight at 4°C, followed by conjugation to the secondary antibody(SP-0023) and DAB(C-0010) staining

Lane 1: Human HeLa cell lysates
Lane 2: Human MCF-7 cell lysates
Lane 3: Human MDA-MB-231 cell lysates
Primary: Anti-MSK1 (bs-2995R) at 1/1000 dilution
Secondary: IRDye800CW Goat Anti-Rabbit IgG at 1/20000 dilution
Predicted band size: 90 kDa
Observed band size: 110 kDa
风险提示:丁香通仅作为第三方平台,为商家信息发布提供平台空间。用户咨询产品时请注意保护个人信息及财产安全,合理判断,谨慎选购商品,商家和用户对交易行为负责。对于医疗器械类产品,请先查证核实企业经营资质和医疗器械产品注册证情况。
文献和实验[IF={{ 4.106 }}] {Ohm AM et al. EGF receptor and PKCδ kinase activate DNA damage-induced pro-survival and pro-apoptotic signaling via biphasic activation of ERK and MSK1 kinases. J Biol Chem. 2019 Mar 22;294(12):4488-4497.} {WB} {Rat}
[IF={{ 1.515 }}] {Sello CT et al. Variations in the expression pattern of HSP27 and MSK1 genes during the development of prehierarchical follicles in the Zi geese (Anser cygnoides). ANNALS OF ANIMAL SCIENCE.2019 ISSN: 2300-8733,} {WB,IHC} {geese}
= NAL), appears to form upon oxidative cyclization of the nonfluorescent 2:1 lysine-HNE Michael adduct-Schiff base cross-link (Scheme 1). Polyclonal antibody (PAb) to the NAL-HNE fluorophore was raised in rabbit and found to be highly specific
GE Healthcare Benzamidine Sepharose™ 6B is p-aminobenzamidine covalently attached to Sepharose 6B by the epoxy coupling method. p-Aminobenzamidine (PAB), is a synthetic inhibitor of trypsin-like serine protease. Trypsin and trypsin
Nucleic Acid Programmable Protein Arrays: Versatile Tools for Array‐Based Functional Protein Studies
.g., Sigma) 50 mg/ml bis‐sulfosuccinimdylsuberate (BS3 ;Pierce, cat. no. PI 21580) in dimethylsulfoxide (DMSO) 5 mg/ml
技术资料暂无技术资料 索取技术资料







